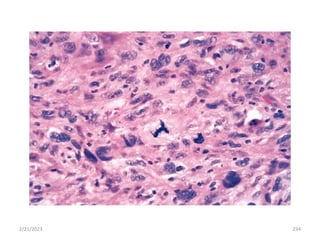
2/21/2023 234

This document provides an introduction to the field of pathology. It defines pathology as the study of disease through scientific methods and discusses how pathology examines the structural, biochemical, and functional changes that underlie disease. The document outlines several key topics in pathology including the core aspects of disease, diagnostic techniques, categories of disease causes, and the course and consequences of diseases. It also provides a brief history of the field and discusses pioneers like Rudolf Virchow. Various cellular responses to injury like adaptation, injury, and death are examined in detail.
























































































![ The extracellular matrix consists[ECM]
The structural fibrous proteins (collagen, elastin),
Adhesive glycoproteins (fibronectin, laminin,
nonfibrillar collagen, Tenascin, and others)
Proteoglycans.
2/21/2023 89](https://image.slidesharecdn.com/pathologypresentationbydrjabessa-240214124440-b00f15bd/85/Pathology-presentation-by-Dr-Jabessa-pptx-89-320.jpg)